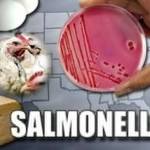
Сальмонеллез

На первый взгляд головная боль, понос и высокая температура имеют мало общего: температура повышается обычно при вирусных инфекциях дыхательных путей.
В тоже время понос свидетельствует о кишечных расстройствах, а головная боль бывает при повышении артериального давления или переутомлении.
В действительности врачам нередко приходится сталкиваться именно с таким сочетанием жалоб пациентов.
Подобные симптомы могут говорить о развитии самых разных заболеваний в организме. И каждый из них очень важен при постановке диагноза.
Так, например, понос – это симптом пищевого отравления или дизентерии. Но если к нему присоединяется высокая температура, можно также подозревать брюшной тиф или ротавирус. Головная боль является одним из типичных признаков общей интоксикации организма, и может сопровождать практически любую патологию.
Интоксикация организма возникает как при отравлении продуктами или химическими веществами, так и при гриппе. Вызывается она продуктами жизнедеятельности патогенных микроорганизмов, которые активно размножаются при инфекционных заболеваниях.
При каких болезнях возникают головная боль, температура и понос

Медлить нельзя, так как состояние при отсутствии адекватного лечения может стремительно ухудшаться. Только врач установит истинную причину недомогания и подберет необходимые медикаменты.
Причины, которые могут вызывать головную боль, понос и высокую температуру:
- Острые бактериальные кишечные инфекции;
- Вирусные инфекции;
- Брюшной тиф.
В некоторых случаях установить возбудителя патологии, которую сопровождают понос, головная боль и температура, невозможно. В этом случае проводится общая терапия для устранения опасных симптомов и нормализации состояния пациента.
Во всех остальных случаях лечение будет зависеть от возбудителя болезни.
Дизентерия
Это достаточно распространенное кишечное заболевание, вызванное инфекцией. Чаще от него страдают в летний сезон, заражение происходит через немытые овощи и фрукты, песок, речную или морскую воду, но возможно и контактное заражение. Высокая температура воздуха способствует активному размножению микробов и стремительному течению болезни.
Основной симптом дизентерии – понос. Возникает по причине поражения толстого кишечника бактерией шигеллезой. Проявляется дизентерия такими симптомами:
- Тошнота и рвота.
- Понос и частые позывы к опорожнению кишечника.
- Отвращение к пище.
- Высокая температура тела.
- Сильная головная боль.
- Учащенное сердцебиение.
Вначале зараженного человека лихорадит, появляются кишечные расстройства, рези в животе, стул жидкий и водянистый. В каловых массах могут быть примеси крови или слизи. Головная боль при ОРВИ возникает позднее, на фоне интоксикации организма.
Острая дизентерия развивается за 1-2 суток, основная опасность заключается в быстром обезвоживании организма из-за практически непрерывной диареи.
Возможны такие осложнения, как растяжение и выпадение прямой кишки, острая почечная недостаточность, не исключается летальный исход при отсутствии своевременной медицинской помощи.
Сальмонеллез
Это заболевание также является острой кишечной инфекцией, но вызывает его сальмонелла. Пути заражения те же, что и при дизентерии:
- Орально-фекальный;
- Пищевой;
- Бытовой.
Основным и первым симптомом сальмонеллеза является диарея и другие пищевые расстройства. Каловые массы по цвету и консистенции напоминают болотную тину, они жидкие, зеленоватые, с большим количеством слизи.
Обезвоживание при сильной диарее и рвоте может наступить за несколько часов, пациент сильно ослабевает, могут возникать и головные боли.
Осложнение сальмонеллеза:
- Отек головного мозга.
- Анурия.
- Дисфункция почек.
Для постановки диагноза обязательны лабораторные исследования рвотных и каловых масс, крови и мочи.
Ротавирусная инфекция
Ротавирусная инфекция – это кишечный грипп, вызванный заражением ротавируса. Страдают при этом желудок и кишечник, поэтому кроме классических симптомов гриппа возникают также диарея и рвота.
В отличие от кишечных инфекций, ротавирусом заражаются преимущественно в осенне-зимний сезон. Подхватить инфекцию можно орально-фекальным или воздушно-капельным путем. Инкубационный период может длиться до пяти суток. Потом появляются такие симптомы:
- Диарея и рвота;
- Боли в животе;
- Головные боли и боли в горле при глотании;
- Повышение температуры тела;
- Покраснение слизистой гортани;
- Насморк и заложенность носа.

Поскольку аппетит при такой патологии отсутствует, с прогрессированием заболевания пациент сильно страдает от изнуряющей рвоты на пустой желудок.
Если отмечаются классические симптомы гриппа, но при этом у пациента частый и жидкий стул, в первую очередь подозревается ротавирус.
Но подобные проявления могут возникать также при инфицировании аденовирусом, астровирусом, норовирусом. Точно определить возбудителя можно только с помощью лабораторных исследований.
Поэтому при подозрении на ротавирус или любой другой, когда к симптомам гриппа присоединяются расстройства со стороны пищеварительной системы, больной госпитализируется в обязательном порядке.
Методы лечения при поносе, головной боли и температуре
Лечение будет разным в зависимости от возбудителя болезни. При острой кишечной инфекции терапия включает такие моменты:
- Соблюдение постельного режима.
- Диета – в первый день можно только подсоленный рис на воде, рисовый отвар, некрепкий сладкий чай, сухарики, потом постепенно вводятся «тощее» картофельное пюре, протертые отварные овощи и супы. Воспрещены кисломолочные продукты, мясо, рыба, кондитерские изделия, газировка.
- Прием антибактериальных препаратов – подбираются лекарства из той группы, к которым чувствителен возбудитель болезни, это может быть Бисептол, Левомицитин, Ампициллин, при сальмонеллезе назначаются фторхинолоны.
- Симптоматические препараты при кишечных расстройствах и диарее – Лоперамид, Имодиум.
- Обезболивающие и жаропонижающие средства при температуре и головных болях – Нурофен, Цитрамон, Анальгин.

Тактика лечения ротавирусной инфекции отличается. Вирусы нечувствительны к антибактериальным препаратам, потому их принимать не имеет смысла. В первую очередь пациенту обязательно дают сорбенты, или вводят их внутривенно, если он находится в тяжелом состоянии.
Обязательно проводится дегидратация – восстановление водно-солевого баланса в организме. Очень хороши для этого порошки для приготовления раствора Электролит или Регидрон. Их принимают внутрь. Но если обезвоживание очень сильное, то больной госпитализируется и ему вводят внутривенно физраствор и глюкозу.
Температуру при ротавирусе не снижают, если она не выше 38,5 градусов – именно при такой температуре вирусы гибнут, если ее сбить, лечение может значительно затянуться. Нужно придерживаться строгой диеты, исключаются все продукты, которые могут раздражать желудок и кишечник, в том числе и кисло-молочные.
Противовирусные препараты принимаются только после того, как остановлены рвота и диарея, иначе активные вещества просто не будут успевать усваиваться.
Если головная боль и температура сопровождаются поносом, это в большинстве случаев связано с кишечными бактериальными инфекциями. Иногда при заражении вирусами может поражаться желудочно-кишечный тракт.
Важно не допустить обезвоживания организма, поэтому следует сразу же обращаться к врачу и делать анализы, чтобы наверняка установить возбудителя инфекции и начать лечение как можно раньше. Подробно о ротавирусной инфекции расскажет видео в этой статье.
https://youtube.com/watch?v=O4AjkJqAiWo
Источник
Кишечное расстройство – проблема, которая может запросто отразиться на ваших планах, испортив настроение и общее самочувствие. Дело обстоит гораздо серьезнее, когда оно сопровождается дополнительными симптомами, например, болевыми ощущениями в голове, кружением, лихорадкой, жаром. Почему возникает понос и головная боль одновременно, может сказать только врач, он же и назначает схему лечебного процесса.
Причины
Диарея, сопровождающаяся головной болью, может выступать в качестве итога нервного напряжения, истощения эмоционального характера, беременности. В этом случае симптоматика исчезнет, как только пациент устранит личные переживания и сможет успокоиться. Серьезный оборот ситуация принимает в случае патологических предпосылок подобного состояния. Их перечень будет представлен ниже.
Интоксикация организма
Съеденный некачественный продукт питания способен обернуться не только поносом, но и общей слабостью, включая боль в голове. Проявления симптоматики в основном зависят от количества съеденной пищи и степени ее вредности. Первые признаки отравления дают о себе знать спустя 1-2 часа с момента потребления испорченного или плохо обработанного продукта. Они заключаются в следующих состояниях:
- диарея;
- выраженная боль в голове;
- общая слабость тела;
- рвотные позывы;
- боли, рези, колики в животе;
- лихорадка, жар;
- кишечные спазмы.
Лечение состоит в оказании организму помощи в процессе вывода вредных агентов путем промывания желудка, проведения клизмы, приема слабительных препаратов и абсорбентов.
Ротавирусная инфекция
https://youtube.com/watch?v=3p-t33kUK64
Болезнь может быть подхвачена через грязные руки, непосредственный контакт с зараженным индивидуумом, потребление водопроводной воды, не прошедшей стадию кипячения, поедание немытых плодов. В простонародье заболевание обрело название «кишечного гриппа», основной его симптом – многократная диарея, выступающая в качестве попытки организма избавиться от основного возбудителя. Процесс не требует борьбы, т. к. пройдет самостоятельно после ликвидации основной причины расстройства. Клиническая картина дополняется следующими состояниями:
- обильная тошнота и рвота, осложняющая лечение пероральными медикаментами;
- симптомы интоксикации организма в виде повышенной температуры тела, головной боли, головокружения, утомляемости и слабости;
- неприятные чувства в животе, что говорит о плохом реагировании этого органа на медикаментозные или народные тактики лечения;
- изменения, затрагивающие каловые массы: они становятся желтоватыми, наделенными кисловатым запахом;
- иногда появляются признаки простуды – покраснение в области горла, кашель, насморк.
Терапия этого инфекционного процесса осуществляется строго под контролем специалиста, т. к. самостоятельные попытки избавиться от него чреваты осложнением и продолжительным приходом выздоровления.
Сальмонеллез
Несоблюдение правил и принципов рационального питания может выступать в качестве причинного фактора формирования бактериальной инфекции, спровоцированной сальмонеллами. Клиническая картина разнообразна и сопровождается следующими симптомами:
- понос;
- боль в голове;
- рвота;
- повышение телесной температуры;
- сильная резь в животе;
- слабость мышц.
В фекалиях содержится огромное количество слизи, и они обретают темно-зеленый тон. Традиционно в качестве источников возбудителей выступают мясные продукты, недоваренные яйца, кисломолочные виды пищи, салаты с майонезом, купленные в магазине. Базовые принципы терапии заключаются в профессиональном подходе, узкой направленности, срочности. Необходима борьба с причиной, породившей патологию. Для этого применяются абсорбенты, обеспечивается обильный питьевой режим.
Дизентерия
Источник поражения – проникновение в человеческий организм дизентерийной палочки. Способ заражения – через фекалии и ротовую полость. Возбуждающий агент ведет свою жизнедеятельность в области толстого кишечника. Наиболее яркой клиническая картина является на начальных порах заболевания – в течение первой недели. Она сопровождается следующими симптомами:
- диарея, достигающая 30 раз в сутки;
- боль в голове;
- лихорадочное состояние;
- режущие боли в животе;
- проблемы с работой ритма сердца;
- озноб на фоне повышенной температуры;
- чрезмерная слабость.
Терапия сводится к соблюдению постельного режима и диетического питания. Под контролем медика осуществляются мероприятия по приему противомикробных составов в целях борьбы с возбудителем.
Прочие патологии
Головная боль и понос у взрослого и ребенка могут выступать в качестве следствий следующих заболеваний:
- холецистит;
- панкреатит;
- язвенный процесс;
- аппендицит;
- кишечное повреждение;
- абсцесс гнойной формы;
- тиф брюшной;
- сепсис;
- грипп;
- раковая опухоль.
Диагностика
В процессе диагностики врач определяет характер головной боли (режущая, давящая, пульсирующая), а также узнает как можно больше информации о каловых массах (цвет, наличие дополнительных вкраплений в виде гноя, слизи, крови, форма и консистенция). Немаловажную роль играет частота испражнений и дополнительные симптомы. При необходимости назначается МРТ, КТ, УЗИ в целях исключения патологий внутренних органов, а также сдается анализ кала, слизи и крови, которая в нем присутствует. На основании полученных данных назначается лечение.
Лечение
https://youtube.com/watch?v=1bTu0KeFaWE
Если болит голова, и проявился понос, необходимо срочно принять меры терапии. Они зависят от причины, вызвавшей это состояние.
При пищевом отравлении
- Во избежание обезвоживания больному нужно потреблять как можно больше жидкости. Подойдет теплая вода, теплый зеленый чай, кисель, морс, травяной отвар/настой.
- Чтобы помочь кишечнику очиститься от токсинов, жизнедеятельность которых вызывает диарею, необходимо принимать сорбенты. Самый доступный из них – уголь активированный. Также назначается Энтеросгель, Смекта, Полисорб.
- Восстановить баланс влаги в организме поможет раствор Регидрон. Один пакетик порошка растворяется в литре воды, а затем принимается внутрь в течение суток.
Головная боль при пищевом отравлении – результат сильной интоксикации организма. Как только токсины выйдут наружу, симптом исчезнет. Поэтому прием медикаментов против головной боли нежелателен.
При вирусной диарее
Вирусные явления – распространенные спутники расстройств желудочно-кишечного тракта. При их прогрессировании показано применение следующих препаратов от поноса, головной боли, слабости.
- Средства для профилактики потери электролитов и обезвоживания организма. Чаще всего на практике применяется Регидрон.
- Энтеросорбенты и ферменты – активированный уголь, Смекта, Энтеросгель. Помогают всасывать токсины и оперативно выводить их из организма с калом.
- Пробиотики для нормализации кишечной микрофлоры. Это Линекс, Бифиформ, Витафлор, Нормофлорин.
- Жаропонижающие средства при лихорадке, сопровождающейся головной болью и общим ухудшением самочувствия.
- Для устранения признаков диареи врачи нередко назначают препараты, скрепляющие содержимое кишечника. Это Иммодиум или его бюджетный аналог Лоперамид.
При инфекционной диарее
Если жидкий стул вкупе с головной болью спровоцирован инфекцией, лечение назначает только врач. Обычно терапия носит комплексный характер, предполагающий проведение патогенетической, этиотропной и симптоматической схемы.
- Прием регидратантов для восстановления баланса жидкости обязателен.
- Употребление энтеросорбентов оправдано при сильном поносе. Они эффективно связывают и выводят из тела вредные бактерии и микробные токсичные элементы.
- Пробиотики насыщают организм полезными бактериями и стабилизируют его среду.
- Этиотропные препараты – антибиотики – борются с бактериальной инфекцией, но назначение происходит строго по медицинским показаниями – Левомицитин, Ампициллин, Доксициклин, Метронидазол.
- Для устранения отдельных симптомов принято использовать обезболивающие (Кетанов, Кеторол, Спазмалгон), противорвотные (Эсказин, Торекан) средства.
Стоит ли принимать таблетки от головной боли
Есть лишь несколько практических случаев, в которых таблетки от головной боли могут оказаться эффективными:
- симптомы продолжаются длительное время;
- боль настолько сильная, что мешает продуктивной жизнедеятельности и комфортному отдыху;
- средства назначил врач.
В остальных случаях самостоятельный прием таблеток от головной боли может усугубить симптоматику и привести к осложнениям, а также к затруднению в постановке диагноза.
Источник
Есть много заболеваний, при которых у человека болит голова и начинается понос. Это может быть грипп, отравление, ангина или кишечная инфекция. Чтобы как можно быстрее избавиться от недомогания, необходимо разобраться, почему появились такие симптомы. Только установив причину развития пищевого расстройства и возникновения головных болей, следует приступать к лечению.
Причины головной боли и поноса
Пищевые и медикаментозные отравления часто становятся причиной того, что у человека возникает разжижение стула, сопровождающееся головными болями. Вдыхание ядовитых газов и прием средств бытовой химии – еще один фактор, провоцирующий кишечное расстройство. При этом у больного появляется слабость, понос, его тошнит, у него сильно болит голова. Причиной одновременного появления этих симптомов отравления является интоксикация, которой подвергается организм после того, как в желудок попадают отравляющие вещества.
Специалистами также выделяется несколько заболеваний, при которых у пациента появляются одновременно головная боль и диарея.
Простудные заболевания
Давящая боль в голове – частый симптом простуды. Интоксикация практически всегда сопровождает такие заболевания, так как вирусы, проникая в кровь, стремительно размножаются, выделяя токсины. Также у многих пациентов возникает диарея из-за подъема температуры, приема большого количества лекарственных средств.
Причинами одновременного поноса и головной боли могут быть следующие заболевания:
- Грипп.
- Ангина.
- ОРВИ.
Важно! Головная боль и расстройство пищеварения появляются при менингите. Это серьезное заболевание, при котором поражается головной мозг. Оно может иметь бактериальное, грибковое или вирусное происхождение.
Причиной появления симптомов интоксикации (диареи и болей в голове) также является герпетическая инфекция. Другие признаки заболевания: жжение, зуд и болезненность в месте высыпаний, повышение температуры тела, увеличение лимфатических узлов.
Кишечные инфекции
Через грязные руки, немытые овощи, неправильно приготовленную пищу человек может заразиться кишечной инфекцией. Бактерии содержатся в сырой воде, сыром мясе, яйцах. Попадая в организм человека, они начинают размножаться, подавляя рост полезной микрофлоры кишечника. Болезнетворные микробы выделяют токсины, оставляют продукты распада. Все это приводит к острой интоксикации, характеризующейся головной болью и диареей.
Причиной возникновения недомогания бывает:
- Сальмонеллез.
- Дизентерия.
- Ботулизм.
- Ротавирусная инфекция.
- Энтеровирусная инфекция
К дополнительным симптомам кишечных инфекций относится тошнота, рвота, у человека может несколько дней болеть голова, долго не прекращается понос.
Путь передачи вирусной и бактериальной инфекций: через кал, рвотные массы. При скоплении большого количества людей возможна передача вируса воздушно-капельным путем.
Глистные инвазии
Глисты передаются от человека к человеку, через продукты питания, воду. Больной, страдающий от гельминтоза, может жаловаться на дискомфорт в животе, понос, частые головные боли. Причиной появления недомогания является интоксикация, которую провоцирую глисты, повреждающие слизистую ЖКТ, выделяе продукты распада в кишечник.
Сепсис
Природа развития сепсиса инфекционная: при попадании в кровь инфекционных агентов у человека развивается системная воспалительная реакция. Основная причина заражения – сильное снижение иммунитета.
Признаки сепсиса:
- Повышение температуры до 40ºC.
- Септический понос.
- Тошнота, рвота.
- Головная боль.
При сепсисе падает кровяное давление, у пациента краснеют белки глаз, возбуждение сменяется заторможенностью. Для лечения заболевания требуются антибиотики, которые вводят больному только в условиях стационара под контролем врача.
Клинические проявления отравления
Если у взрослого пациента начался понос и болит голова, нужно как можно быстрее установить, что именно спровоцировало недомогание. Для этого желательно обратить внимание на клинические проявления, сопровождающие расстройство пищеварения
При отравлении некачественной пищей у больного появляется:
- Боль в правом подреберье.
- Тошнота.
- Рези в кишечнике.
- Понос.
- Рвота.
Головная боль присоединяется к симптомам позже, когда возрастает интоксикация организма. При отравлении грибами неприятные ощущения в животе сохраняются продолжительный период, дольше болит голова, у пациента падает пульс и растет температура.
При отравлении угарным газом головная боль – основной признак. Она давит в височной, лобной части, опоясывает голову. Также появляются симптомы интоксикации организма: тошнота, рвота, иногда диарея.
Когда нужно срочно обратиться к врачу
В домашних условиях можно облегчить состояние, принимая обезболивающие препараты и противодиарейные средства. Но бывают ситуации, требующие повышенного внимания врача.
В срочном порядке нужно обращаться в скорую помощь, если:
- В кале появилась кровь, обильная слизь.
- Рвота долго не прекращается, в рвотных массах кровь.
- По телу пошла сыпь неизвестного происхождения.
- Голова болит невыносимо, обезболивающие препараты не помогают.
- Температура тела значительно возросла, на градуснике показывает более 38,5ºC.
- Диарея не прекращается дольше 5 дней.
- У человека отсутствует мочеиспускание.
- Появились обмороки, спутанность сознания.
Особенно опасно, когда у ребенка болит голова и долгое время не проходит понос, так как головная боль при расстройстве пищеварения может быть признаком сильного обезвоживания.
Лечение
Лекарственные препараты для устранения кишечных расстройств необходимо обязательно согласовать с врачом. Главная задача – снять интоксикацию и восстановить водно-солевой баланс.
Когда у человека болит голова и появился жидкий стул из-за пищевого отравления, в первую очередь следует устранить из организма продукт, провоцирующий интоксикацию. Для этого проводят промывание желудка с помощью таблеток Активированного угля или раствора Марганцовки.
В дальнейшем больному назначаются следующие препараты:
- Нормогидрон, Регисол, Орсоль, Регидрон. Эти лекарства способствуют восстановлению водно-солевого баланса.
- Полисорб, Полифепан, Максисорб, Смекта, Сорбентогель. Назначение лекарственных средств – связывание токсинов, вирусов, аллергенов и их вывод из кишечника.
Чтобы снизить болевые ощущения, пациент может принять таблетку Парацетамола, Анальгина. При простудных заболеваниях от головной боли помогает Ибуфен.
Важно! Нельзя просто ждать, пока прекратятся рвота и понос и перестанет болеть голова, принимая самостоятельно выбранные лекарства. Если прием препаратов не помогает, следует в срочном порядке обратиться за врачебной помощью.
Профилактические меры
Избежать появления диареи и головной боли можно, если питаться правильно. Для профилактики пищевых отравлений рекомендуется:
- Покупать только свежие продукты.
- Термически обрабатывать рыбу, яйца и мясо.
- Мыть фрукты и овощи перед употреблением.
- Пить бутилированную, кипяченую воду.
- Отказаться от перекусов на ходу, в подозрительных кафе, точках питания.
- Не есть консервированные продукты, приобретенные «с рук».
В сезон простуд следует отказаться от посещения мест с большим скоплением людей. От гриппа можно сделать прививку, а профилактику ОРВИ проводить с помощью Оксолиновой мази. Соблюдение правил личной гигиены также поможет избежать заражения инфекциями: следует обязательно мыть руки и лицо с мылом после посещения общественных мест.
Источник